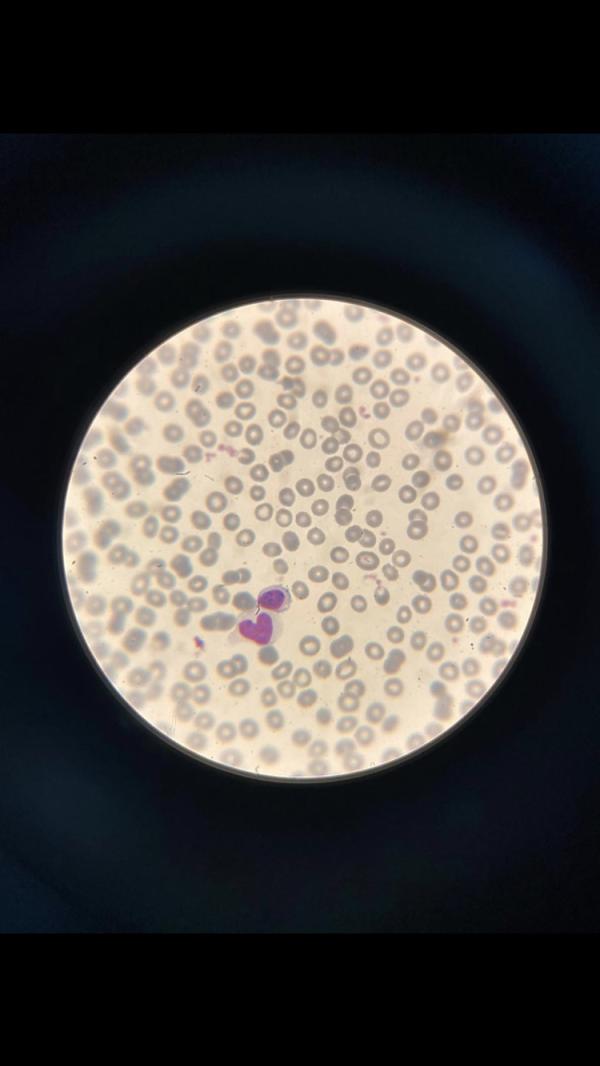
post image

milalii
Мila·Мама двоих (младенец)

Женщина слабее всего, когда любит кого-то, и сильнее всего, когда кем-то любима.😋🥰
1
Симптомы лейкоза у детей

Опыт решения запоров у малышей до 3-х лет.

Как Pigeon сохраняет близость между мамой и малышом

Женщина слабее всего, когда любит кого-то, и сильнее всего, когда кем-то любима.😋🥰


